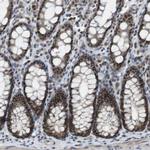
PRAK Antibody in Immunohistochemistry (Paraffin) (IHC (P))

Search
Invitrogen
PRAK Polyclonal Antibody
{{$productOrderCtrl.translations['antibody.pdp.commerceCard.promotion.promotions']}}
{{$productOrderCtrl.translations['antibody.pdp.commerceCard.promotion.viewpromo']}}
{{$productOrderCtrl.translations['antibody.pdp.commerceCard.promotion.promocode']}}: {{promo.promoCode}} {{promo.promoTitle}} {{promo.promoDescription}}. {{$productOrderCtrl.translations['antibody.pdp.commerceCard.promotion.learnmore']}}
产品信息
PA5-82529
种属反应
宿主/亚型
分类
类型
抗原
偶联物
形式
浓度
规格
纯化类型
保存液
内含物
保存条件
运输条件
RRID
产品详细信息
Immunogen sequence: PLHSVNNPIL RKRKLLGTKP KDSVYIHDHE NGAEDSNVAL EKLRDVIAQC ILPQAGKGEN EDEKLNEVMQ EAWKYNRECK LLRDTLQSFS WNGRGFTDKV DRLKLAEIVK QVIEEQTTSH
Highest antigen sequence indentity to the following orthologs: Rat - 94%, Mouse - 94%.
靶标信息
MAPKAPK5 (PRAK) is activated in response to cellular stress and pro-inflammatory cytokines. Activity of this kinase is regulated by p38 alpha and p38 beta. The protein encoded by PRAK is a member of the serine/threonine kinase family. In response to cellular stress and proinflammatory cytokines, this kinase is activated through its phosphorylation by MAP kinases including MAPK1/ERK, MAPK14/p38-alpha, and MAPK11/p38-beta. In vitro, this kinase phosphorylates heat shock protein HSP27 at its physiologically relevant sites. Two alternately spliced transcript variants of PRAK encoding distinct isoforms have been reported.
仅用于科研。不用于诊断过程。未经明确授权不得转售。
篇参考文献 (0)
生物信息学
蛋白别名: MAP kinase-activated protein kinase 5; MAPK-activated protein kinase 5; MAPKAP kinase 5; MAPKAPK-5; mitogen-activated protein kinase-activated protein kinase 5; p38-regulated/activated protein kinase; PRAK; unnamed protein product
基因别名: MAPKAP-K5; MAPKAPK5; MK-5; MK5; NCFD; PRAK
UniProt ID: (Human) Q8IW41
Entrez Gene ID: (Human) 8550